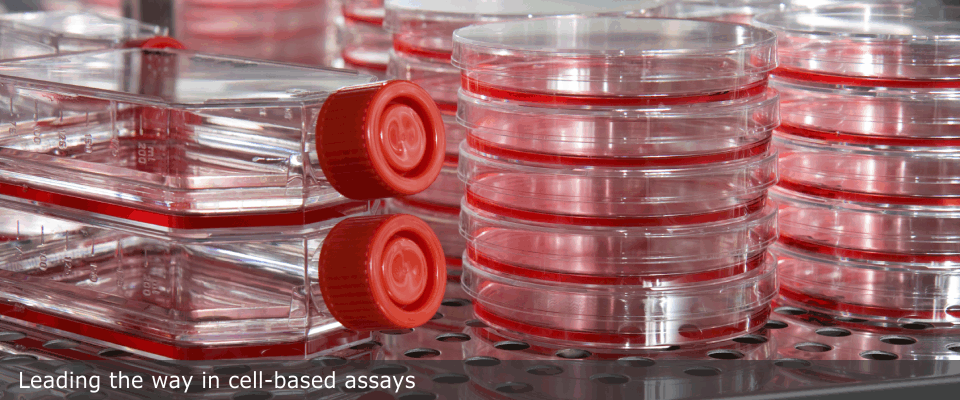
testimg

Cell-based Assay Contract Research Services
Established in 2007, Xeno Diagnostics is a leading Contract Research Organization (CRO) specializing in custom cell-based assays in the area of immunological testing. From mixed-lymphocyte reactions (MLR's), to cytotoxicity and cytokine testing, Xeno Diagnostics has experience in a wide variety of in-vitro diagnostic testing. Xeno has performed contract research with human, non-human primate (baboon, cynomolgous macaque, rhesus macaque), and porcine models. Xeno has consistently demonstrated the ability to produce high-quality, reliable data. Xeno is an accredited high-complexity CLIA laboratory with the ability to run studies under Good Laboratory Practices (GLP) or non-GLP conditions. While many of our services are listed on our website, we encourage visitors to return often as we have many new service offerings in the pipeline. Feel free to inquire about products or services that aren’t listed. Thank you for your interest, and welcome to Xeno Diagnostics!
Contract laboratory services:
Additional lab services:
- Cell-based Assays and Services
- Mixed Lymphocyte Reactions (MLR)
- Cytotoxicity (Antibody-dependent complement-mediated)
- Phagocytosis
- Cell Viability
- Stem-cell Enumeration (human)
- T Cell Isolation
- PBMC Isolation
- Cell Expansion
- Receptor Occupancy Assays
- Cryopreservation and Storage
- Enzyme-linked Immunosorbant Assays (ELISA's)
- Baboon-specific Analytes
- Cynomolgus Macaque-specific Analytes
- Rhesus Macaque-specific Analytes
- Custom Assay Development
- Other Capabilities
- Commercial Flow Cytometry
- Cell culture
If you don't see the assay you need listed above, click here to search our services. Or click here to learn more about our contract research process.
Still don't see what you need? Click here to ask us a question, or give us a call at (317) 973-4079.